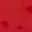

Prodotti all'ingrosso di Lina Lind
Prodotti all'ingrosso di Lina Lind
Prodotti all'ingrosso di Lina Lind
Trova prodotti per il tuo negozio nei cataloghi di migliaia di brand.
Accedi ai prezzi all'ingrossoInformazioni su Lina Lind
Lina Lind Il giovane marchio di lingerie europeo con sede ad Amburgo. Un team di designer europei crea e rinnova due giovani collezioni. Lingerie sexy classica con elevati standard di qualità e una linea clubwear per gli amanti della brillantezza, del comfort e di una seconda pelle aderente. Entrambe le linee sono moderne, audaci e al passo con i tempi. Lina va per la sua strada. Lina Lind ha iniziato la sua vita a 90 stili. Non solo i design sono rapidamente moderni, ma Lina ha anche il suo stile per varie occasioni. TZ Fashion di Amburgo è l'azienda che Lina Lind disegna e produce in proprio. Lina Lind è presente al Salon International de la Lingerie di Parigi e al Supreme Munich. Oltre ai 90 modelli, offriamo anche il vantaggio di avere una produzione propria (al di fuori dell'Europa) alla quale abbiamo accesso diretto e possiamo quindi controllare e monitorare tempi, qualità e quantità di consegna in modo mirato. È possibile implementare tempi di consegna a breve termine per quantità ancora maggiori. Siamo consapevoli della nostra responsabilità nei vostri confronti come clienti e attribuiamo la massima importanza alla qualità e all'affidabilità delle consegne.